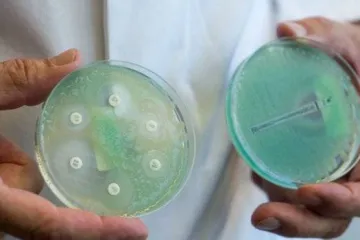

Մունդիալ-2026․ մեկնարկն արդարացնո՞ւմ է սպասելիքները
Մունդիալ-2026․ մեկնարկն արդարացնո՞ւմ է սպասելիքները Մինիոնները վերադառնում են
Մինիոնները վերադառնում են Apple-ը թանկացնելու է իր արտադրանքը
Apple-ը թանկացնելու է իր արտադրանքը Ռուս-ուկրաինական հակամարտությունն ազդում է Եվրոպայի և ՆԱՏՕ-ի անվտանգության վրա. Գյուլեր
Ռուս-ուկրաինական հակամարտությունն ազդում է Եվրոպայի և ՆԱՏՕ-ի անվտանգության վրա. Գյուլեր Եվս մեկ կուսակցություն է դիմել ՍԴ ընտրությունների արդյունքները չեղարկելու պահանջով
Եվս մեկ կուսակցություն է դիմել ՍԴ ընտրությունների արդյունքները չեղարկելու պահանջով Ռուբեն Հակոբյանի կալանավորման վերաբերյալ ՔԿ-ն մանրամասներ է հայտնել
Ռուբեն Հակոբյանի կալանավորման վերաբերյալ ՔԿ-ն մանրամասներ է հայտնել «Այրվող Մոսկվան» վկայում է պատերազմում տեղի ունեցած փոփոխությունների մասին․ միջազգային մամուլի անդրադարձը
«Այրվող Մոսկվան» վկայում է պատերազմում տեղի ունեցած փոփոխությունների մասին․ միջազգային մամուլի անդրադարձը Գաղտնալսումները՝ հիմնավոր կասկածների դեպքում՝ դատարանի վճռով․ ընտրակեղծիքի 17 գործ հասել է դատարան
Գաղտնալսումները՝ հիմնավոր կասկածների դեպքում՝ դատարանի վճռով․ ընտրակեղծիքի 17 գործ հասել է դատարան ԲՀԿ-ն դիմել է ՍԴ՝ վիճարկելու ընտրությունների արդյունքները
ԲՀԿ-ն դիմել է ՍԴ՝ վիճարկելու ընտրությունների արդյունքները «Հանուն Հանրապետության ժողովրդավարության պաշտպանների դաշինքը» ՍԴ է դիմել՝ վիճարկելու ԱԺ ընտրությունների արդյունքները
«Հանուն Հանրապետության ժողովրդավարության պաշտպանների դաշինքը» ՍԴ է դիմել՝ վիճարկելու ԱԺ ընտրությունների արդյունքները Եթե քաղաքացին 2026-ին օգտվել է ատամնաբուժական ծառայությունից, 2027-ին կարո՞ղ է ստանալ սոցիալական ծախսի փոխհատուցում. ՊԵԿ պարզաբանում
Եթե քաղաքացին 2026-ին օգտվել է ատամնաբուժական ծառայությունից, 2027-ին կարո՞ղ է ստանալ սոցիալական ծախսի փոխհատուցում. ՊԵԿ պարզաբանում «Մի նոր փոդքաստ պարտադիր դիտման համար» հյուր՝ Ռուբեն Ռուբինյան թողարկում 10
«Մի նոր փոդքաստ պարտադիր դիտման համար» հյուր՝ Ռուբեն Ռուբինյան թողարկում 10 Վահան Կոստանյանն ընդունել է ՀՀ-ում ԵՄ գործընկերության առաքելության նորանշանակ ղեկավարին
Վահան Կոստանյանն ընդունել է ՀՀ-ում ԵՄ գործընկերության առաքելության նորանշանակ ղեկավարին Ռուսաստանի և Ուկրաինայի միջև փոխադարձ հարվածները շարունակվում են
Ռուսաստանի և Ուկրաինայի միջև փոխադարձ հարվածները շարունակվում են Հրապարակվել են հունիսի 7-ին կայացած ԱԺ հերթական ընտրությունների վիճակագրական տվյալները․ ԿԸՀ
Հրապարակվել են հունիսի 7-ին կայացած ԱԺ հերթական ընտրությունների վիճակագրական տվյալները․ ԿԸՀ Կասեցվել է Ուռուտ գյուղում գործող պանրի արտադրամասի գործունեությունը․ ՍԱՏՄ
Կասեցվել է Ուռուտ գյուղում գործող պանրի արտադրամասի գործունեությունը․ ՍԱՏՄ ԱԺ ընտրությունների արդյունքները վիճարկող դիմումը մուտքագրվել է ՍԴ․ ընդունելիության հարցը կքննարկվի 2 օրում
ԱԺ ընտրությունների արդյունքները վիճարկող դիմումը մուտքագրվել է ՍԴ․ ընդունելիության հարցը կքննարկվի 2 օրում Բյուրականի աստղադիտարանի ձեռքբերումները ներկայացվել են միջազգային դիվանագիտական համայնքին
Բյուրականի աստղադիտարանի ձեռքբերումները ներկայացվել են միջազգային դիվանագիտական համայնքին Հայաստանը մասնակցել է ՅՈՒՆԵՍԿՕ-ի ոչ նյութական մշակութային ժառանգության 11-րդ նստաշրջանին
Հայաստանը մասնակցել է ՅՈՒՆԵՍԿՕ-ի ոչ նյութական մշակութային ժառանգության 11-րդ նստաշրջանին Ամառային տապ և ջերմային հարված. ի՞նչ է պետք իմանալ առողջությունը պաշտպանելու համար
Ամառային տապ և ջերմային հարված. ի՞նչ է պետք իմանալ առողջությունը պաշտպանելու համար «Դեմոկրատիա, օրենք, կարգապահություն» կուսակցությունը ՍԴ է դիմել՝ վիճարկելու ԱԺ ընտրությունների արդյունքները
«Դեմոկրատիա, օրենք, կարգապահություն» կուսակցությունը ՍԴ է դիմել՝ վիճարկելու ԱԺ ընտրությունների արդյունքները Վարչապետը ներկա է եղել Երևանի Հակոբ Կոջոյանի անվան վերակառուցված կրթահամալիրի բացման արարողությանը
Վարչապետը ներկա է եղել Երևանի Հակոբ Կոջոյանի անվան վերակառուցված կրթահամալիրի բացման արարողությանը «Ուժեղ Հայաստան»-ի համակիրը օրենսդրական արգելքի պայմաններում բաժանել է ընտանի կենդանիներ և թռչուններ. ՀԿԿ-ն ձայնագրություն է հրապարակել
«Ուժեղ Հայաստան»-ի համակիրը օրենսդրական արգելքի պայմաններում բաժանել է ընտանի կենդանիներ և թռչուններ. ՀԿԿ-ն ձայնագրություն է հրապարակել Հունիսի 23-ին կմեկնարկի առաջին դասարան հաճախող երեխաների հայտագրման հիմնական փուլը
Հունիսի 23-ին կմեկնարկի առաջին դասարան հաճախող երեխաների հայտագրման հիմնական փուլը Ռուբեն Հակոբյանը ձերբակալվել է. ՔԿ-ն մանրամասներ է հայտնել
Ռուբեն Հակոբյանը ձերբակալվել է. ՔԿ-ն մանրամասներ է հայտնել «Միասնության թևեր»-ը ՍԴ է դիմել՝ վիճարկելու ԱԺ ընտրությունների արդյունքները
«Միասնության թևեր»-ը ՍԴ է դիմել՝ վիճարկելու ԱԺ ընտրությունների արդյունքները ԵՄ-ն Հայաստանին տրամադրում է 34 միլիոն եվրոյի անհետաձգելի աջակցություն՝ նախագահ Ֆոն դեր Լայենի հայտարարությանը համապատասխան
ԵՄ-ն Հայաստանին տրամադրում է 34 միլիոն եվրոյի անհետաձգելի աջակցություն՝ նախագահ Ֆոն դեր Լայենի հայտարարությանը համապատասխան Մակրոնը խոստովանել է, որ օգտագործում է արհեստական բանականություն
Մակրոնը խոստովանել է, որ օգտագործում է արհեստական բանականություն Կավ, փայտ և հայկական ձեռագիր․ Վերնիսաժի կոլորիտը
Կավ, փայտ և հայկական ձեռագիր․ Վերնիսաժի կոլորիտը Իրանն ԱՄՆ-ի հետ բանակցությունները վերսկսելուց առաջ երաշխիքներ է պահանջել Լիբանանում ռազմական գործողությունների դադարեցման առնչությամբ. CNN
Իրանն ԱՄՆ-ի հետ բանակցությունները վերսկսելուց առաջ երաշխիքներ է պահանջել Լիբանանում ռազմական գործողությունների դադարեցման առնչությամբ. CNN Իգլեսիասը ստիպված է եղել ապացուցել, որ ինքն Իսպանիայի հավաքականի ֆուտբոլիստ է
Իգլեսիասը ստիպված է եղել ապացուցել, որ ինքն Իսպանիայի հավաքականի ֆուտբոլիստ է Սկանդալ հայկական ֆուտբոլում․ «Նոան» պահանջում է համակարգային փոփոխություններ ՀՖՖ-ում
Սկանդալ հայկական ֆուտբոլում․ «Նոան» պահանջում է համակարգային փոփոխություններ ՀՖՖ-ում NASA-ի գաղտնազերծված նյութերը նոր շոկային քննարկում են առաջացրել Լուսնի մասին
NASA-ի գաղտնազերծված նյութերը նոր շոկային քննարկում են առաջացրել Լուսնի մասին Իտալիայի վարչապետը հայտնել է, որ թողել է ծխելը
Իտալիայի վարչապետը հայտնել է, որ թողել է ծխելը Քաջարան-Ագարակ հատվածի թունելում մեկնարկել է բետոնացման փուլը
Քաջարան-Ագարակ հատվածի թունելում մեկնարկել է բետոնացման փուլը ԵՄ-ում ներքին ճգնաժամ է. դժգոհ են Մոսկվայի հետ գաղտնի բանակցություններից
ԵՄ-ում ներքին ճգնաժամ է. դժգոհ են Մոսկվայի հետ գաղտնի բանակցություններից Բոլորը կհաշտվեն այն մտքի հետ, որ ընտրություններն անցել են ազատ, թափանցիկ և լեգիտիմ ճանապարհով․ Ալխաս Ղազարյան
Բոլորը կհաշտվեն այն մտքի հետ, որ ընտրություններն անցել են ազատ, թափանցիկ և լեգիտիմ ճանապարհով․ Ալխաս Ղազարյան Մեկնարկում է «Մանկական Եվրատեսիլ 2026»-ի հայաստանյան ներկայացուցչի ընտրության մրցույթը
Մեկնարկում է «Մանկական Եվրատեսիլ 2026»-ի հայաստանյան ներկայացուցչի ընտրության մրցույթը Ավստրալիան Ուկրաինային կհատկացնի ևս 70 մլն դոլար՝ զենք գնելու համար
Ավստրալիան Ուկրաինային կհատկացնի ևս 70 մլն դոլար՝ զենք գնելու համար Ջրվեժում բախվել են «Mercedes»-ը և «Opel Zafira»-ն. կան վիրավորներ
Ջրվեժում բախվել են «Mercedes»-ը և «Opel Zafira»-ն. կան վիրավորներ «Հայաստան» դաշինքից Ռուսլան Բարսեղյանը կալանավորվեց 2 ամսով, Ասատուր Քոչարյանի նկատմամբ կիրառվեց տնային կալանք
«Հայաստան» դաշինքից Ռուսլան Բարսեղյանը կալանավորվեց 2 ամսով, Ասատուր Քոչարյանի նկատմամբ կիրառվեց տնային կալանք Աշտարակ քաղաքի Էջմիածնի խճուղում տեղադրվել է լուսանկարահանող տեխնիկական միջոց
Աշտարակ քաղաքի Էջմիածնի խճուղում տեղադրվել է լուսանկարահանող տեխնիկական միջոց Արմեն Նիկողոսյանը հեռացել է ՀՖՖ փոխնախագահի պաշտոնից
Արմեն Նիկողոսյանը հեռացել է ՀՖՖ փոխնախագահի պաշտոնից Էներգահամակարգերի բաշխման ցանցին միանալու գործընթացը դարձել է առավել պարզ և ճկուն
Էներգահամակարգերի բաշխման ցանցին միանալու գործընթացը դարձել է առավել պարզ և ճկուն Կալասը նշել է, թե երբ է ԵՄ-ն քննարկելու Իրանի նկատմամբ պատժամիջոցների վերացման հարցը
Կալասը նշել է, թե երբ է ԵՄ-ն քննարկելու Իրանի նկատմամբ պատժամիջոցների վերացման հարցը Չեխիան ոչ-ոքի ավարտեց հանդիպումը ՀԱՀ-ի հետ
Չեխիան ոչ-ոքի ավարտեց հանդիպումը ՀԱՀ-ի հետ Մեքսիկան հաղթահարեց խմբային փուլի արգելքը, Կանադան խոշոր հաշվով հաղթեց Կատարին
Մեքսիկան հաղթահարեց խմբային փուլի արգելքը, Կանադան խոշոր հաշվով հաղթեց Կատարին Մեկնարկել է Գյուրջյան փողոցը Մյասնիկյան պողոտային միացնող ճանապարհի հիմնանորոգումը
Մեկնարկել է Գյուրջյան փողոցը Մյասնիկյան պողոտային միացնող ճանապարհի հիմնանորոգումը Փակել փողոց նայող պատուհաններն ու դռները
Փակել փողոց նայող պատուհաններն ու դռները ԿԸՀ-ն Հայաստանում կայացած խորհրդարանական ընտրությունների վերաբերյալ վիճակագրական տվյալներ է հրապարակել
ԿԸՀ-ն Հայաստանում կայացած խորհրդարանական ընտրությունների վերաբերյալ վիճակագրական տվյալներ է հրապարակել Գիտություն
 Բուքինգեմյան պալատում արգելել են պլաստիկ շշերի օգտագործումը
Բուքինգեմյան պալատում արգելել են պլաստիկ շշերի օգտագործումը
 Ֆաստ ֆուդն իրենից ի՞նչ է ներկայացնում եւ ինչո՞ւ է այդքան վտանգավոր
Ֆաստ ֆուդն իրենից ի՞նչ է ներկայացնում եւ ինչո՞ւ է այդքան վտանգավոր
 Ի՞նչ է պետք իմանալ, եթե պլանավորում եք քթի պլաստիկ վիրահատություն
Ի՞նչ է պետք իմանալ, եթե պլանավորում եք քթի պլաստիկ վիրահատություն
 Պարացետամոլը անպտղությո՞ւն է առաջացնում
Պարացետամոլը անպտղությո՞ւն է առաջացնում
 Ազատվում ենք արյան բարձր ճնշումից, խոլեստերինից
Ազատվում ենք արյան բարձր ճնշումից, խոլեստերինից
 Շաբաթ գիշերը Երկրին կմոտենա 40 մետր երկարությամբ աստերոիդ
Շաբաթ գիշերը Երկրին կմոտենա 40 մետր երկարությամբ աստերոիդ
 Tesla Roadster-ը շարժվում է Մարսի ուղղությամբ
Tesla Roadster-ը շարժվում է Մարսի ուղղությամբ
 Հայ գիտնականների հայտնագործությունները ներառվել են РИА Новости-ի՝ աշխարհը ցնցած ...
Հայ գիտնականների հայտնագործությունները ներառվել են РИА Новости-ի՝ աշխարհը ցնցած ...
 Ընկերությունն անձնական ֆիթնեսի հրահանգիչով հայելի է ստեղծել
Ընկերությունն անձնական ֆիթնեսի հրահանգիչով հայելի է ստեղծել
 Դանդաղ խոսիր, բան չեմ հասկանում, այդ ինչե՞ր ես խոսում. ռոբոտը կատաղեցրել է թուրք...
Դանդաղ խոսիր, բան չեմ հասկանում, այդ ինչե՞ր ես խոսում. ռոբոտը կատաղեցրել է թուրք...
 SpaceX-ը հաջողությամբ իրականացրել է Falcon Heavy հրթիռակրի արձակումը
SpaceX-ը հաջողությամբ իրականացրել է Falcon Heavy հրթիռակրի արձակումը
 Մասիսի հիվանդանոցում թեյը հանձնել են որպես մեզի անալիզ եւ ստացել պատասխան
Մասիսի հիվանդանոցում թեյը հանձնել են որպես մեզի անալիզ եւ ստացել պատասխան
 Facebook-ը սելֆիի միջոցով կհաշվի օգտատերերի եկամուտը
Facebook-ը սելֆիի միջոցով կհաշվի օգտատերերի եկամուտը
 Սննդակարգ՝ ըստ արյան խմբի
Սննդակարգ՝ ըստ արյան խմբի
 Ալկոհոլը քաղցկեղի 7 տեսակ է առաջացնում. ԱՀԿ
Ալկոհոլը քաղցկեղի 7 տեսակ է առաջացնում. ԱՀԿ
 Հայտնաբերվել է 4 հազար 400 տարվա դամբարան
Հայտնաբերվել է 4 հազար 400 տարվա դամբարան
 Իրանագիտությունը ծանր կորուստ կրեց
Իրանագիտությունը ծանր կորուստ կրեց
 Գիտնականները պարզել են, թե ինչպես են ծառերը «քրտնում»
Գիտնականները պարզել են, թե ինչպես են ծառերը «քրտնում»
 Շարունակում ենք քիչ երեխա ունենալ եւ արտագաղթել
Շարունակում ենք քիչ երեխա ունենալ եւ արտագաղթել
 Հեռացվեց հսկայական կիստան. Արամյանց ԲԿ-ի պրոֆեսիոնալների լուծումները
Հեռացվեց հսկայական կիստան. Արամյանց ԲԿ-ի պրոֆեսիոնալների լուծումները
 Պիցցան ամենաօգտակար նախաճաշ են ճանաչել
Պիցցան ամենաօգտակար նախաճաշ են ճանաչել
 Ինչու՞ են մարդիկ վստահում անծանոթներին
Ինչու՞ են մարդիկ վստահում անծանոթներին
 Աթեիզմը եւ Աստծո գոյությունը
Աթեիզմը եւ Աստծո գոյությունը
 Քրքումը պաշտպանում է դեմենցիայից. հետազոտություն
Քրքումը պաշտպանում է դեմենցիայից. հետազոտություն
 Ճարպակալումը կարող է վարակի՞չ լինել
Ճարպակալումը կարող է վարակի՞չ լինել
 Կրուիզային ճանապարհորդության առավելությունները
Կրուիզային ճանապարհորդության առավելությունները
 Հնդկաստանում մտադիր են դասաքրքերից հանել էվոլյուցիայի տեսությունը
Հնդկաստանում մտադիր են դասաքրքերից հանել էվոլյուցիայի տեսությունը
 Ինչո՞ւ ենք մենք սխալ ընկալում մեր մարմնի չափը
Ինչո՞ւ ենք մենք սխալ ընկալում մեր մարմնի չափը
 Գիտնականները 2017-ը պատմության երկրորդ ամենաշոգ տարի են ճանաչել
Գիտնականները 2017-ը պատմության երկրորդ ամենաշոգ տարի են ճանաչել
 Միկրոալիքային վառարանները մարդկության համար սպառնալիք են
Միկրոալիքային վառարանները մարդկության համար սպառնալիք են
Վերջին 7 օրվա
Թոփ լուրեր Թոփ 10
ամենաընթերցված
էջերը
 «Զինապահ» հիմնադրամը 2025 թվականի ավարտի դրությամբ հատուցումներ է տրամադրել 5 հազար 510 շահառուի
«Զինապահ» հիմնադրամը 2025 թվականի ավարտի դրությամբ հատուցումներ է տրամադրել 5 հազար 510 շահառուի
1
 Փրկարարները և ոստիկանները Փամբակ գետում շարունակում են որոնողական աշխատանքները
Փրկարարները և ոստիկանները Փամբակ գետում շարունակում են որոնողական աշխատանքները
2
 ԱԹՍ-ների զանգվածային հարձակում Ռուսաստանում․ կրկին հարվածել են Մոսկվայի նավթավերամշակման գործարանին
ԱԹՍ-ների զանգվածային հարձակում Ռուսաստանում․ կրկին հարվածել են Մոսկվայի նավթավերամշակման գործարանին
3
 Հայ դպրոցականների հերթական հաջողությունը
Հայ դպրոցականների հերթական հաջողությունը
4
 Սուրեն Պապիկյանը Փարիզում մասնակցել է «Eurosatory 2026» միջազգային ցուցահանդեսի բացման պաշտոնական ար...
Սուրեն Պապիկյանը Փարիզում մասնակցել է «Eurosatory 2026» միջազգային ցուցահանդեսի բացման պաշտոնական ար...
5
 Ռուբեն Վարդանյանի կինը մտադիր է կազմակերպել կանանց միջազգային մարդասիրական պատվիրակության այց Բաքու
Ռուբեն Վարդանյանի կինը մտադիր է կազմակերպել կանանց միջազգային մարդասիրական պատվիրակության այց Բաքու
6
 Արդեն մոտ 2 ժամ է՝ փրկարարները, ոստիկաններն ու քաղաքացիների Փամբակ գետում որոնում են մոտ 15-ամյա աղջ...
Արդեն մոտ 2 ժամ է՝ փրկարարները, ոստիկաններն ու քաղաքացիների Փամբակ գետում որոնում են մոտ 15-ամյա աղջ...
7
 Մի դիմում էլ մենք ներկայացրինք. Ալեն Սիմոնյանն ու Անելյա Գուբրյանը ամուսնությունը գրանցելու դիմում ե...
Մի դիմում էլ մենք ներկայացրինք. Ալեն Սիմոնյանն ու Անելյա Գուբրյանը ամուսնությունը գրանցելու դիմում ե...
8
 Հակակոռուպցիոն կոմիտեի նախագահը միջնորդություն է ներկայացրել նախարարություն
Հակակոռուպցիոն կոմիտեի նախագահը միջնորդություն է ներկայացրել նախարարություն
9
Ցեմենտի ներմուծումը 6 ամսով կսահմանափակվի
Ցեմենտի ներմուծումը 6 ամսով կսահմանափակվի
10



